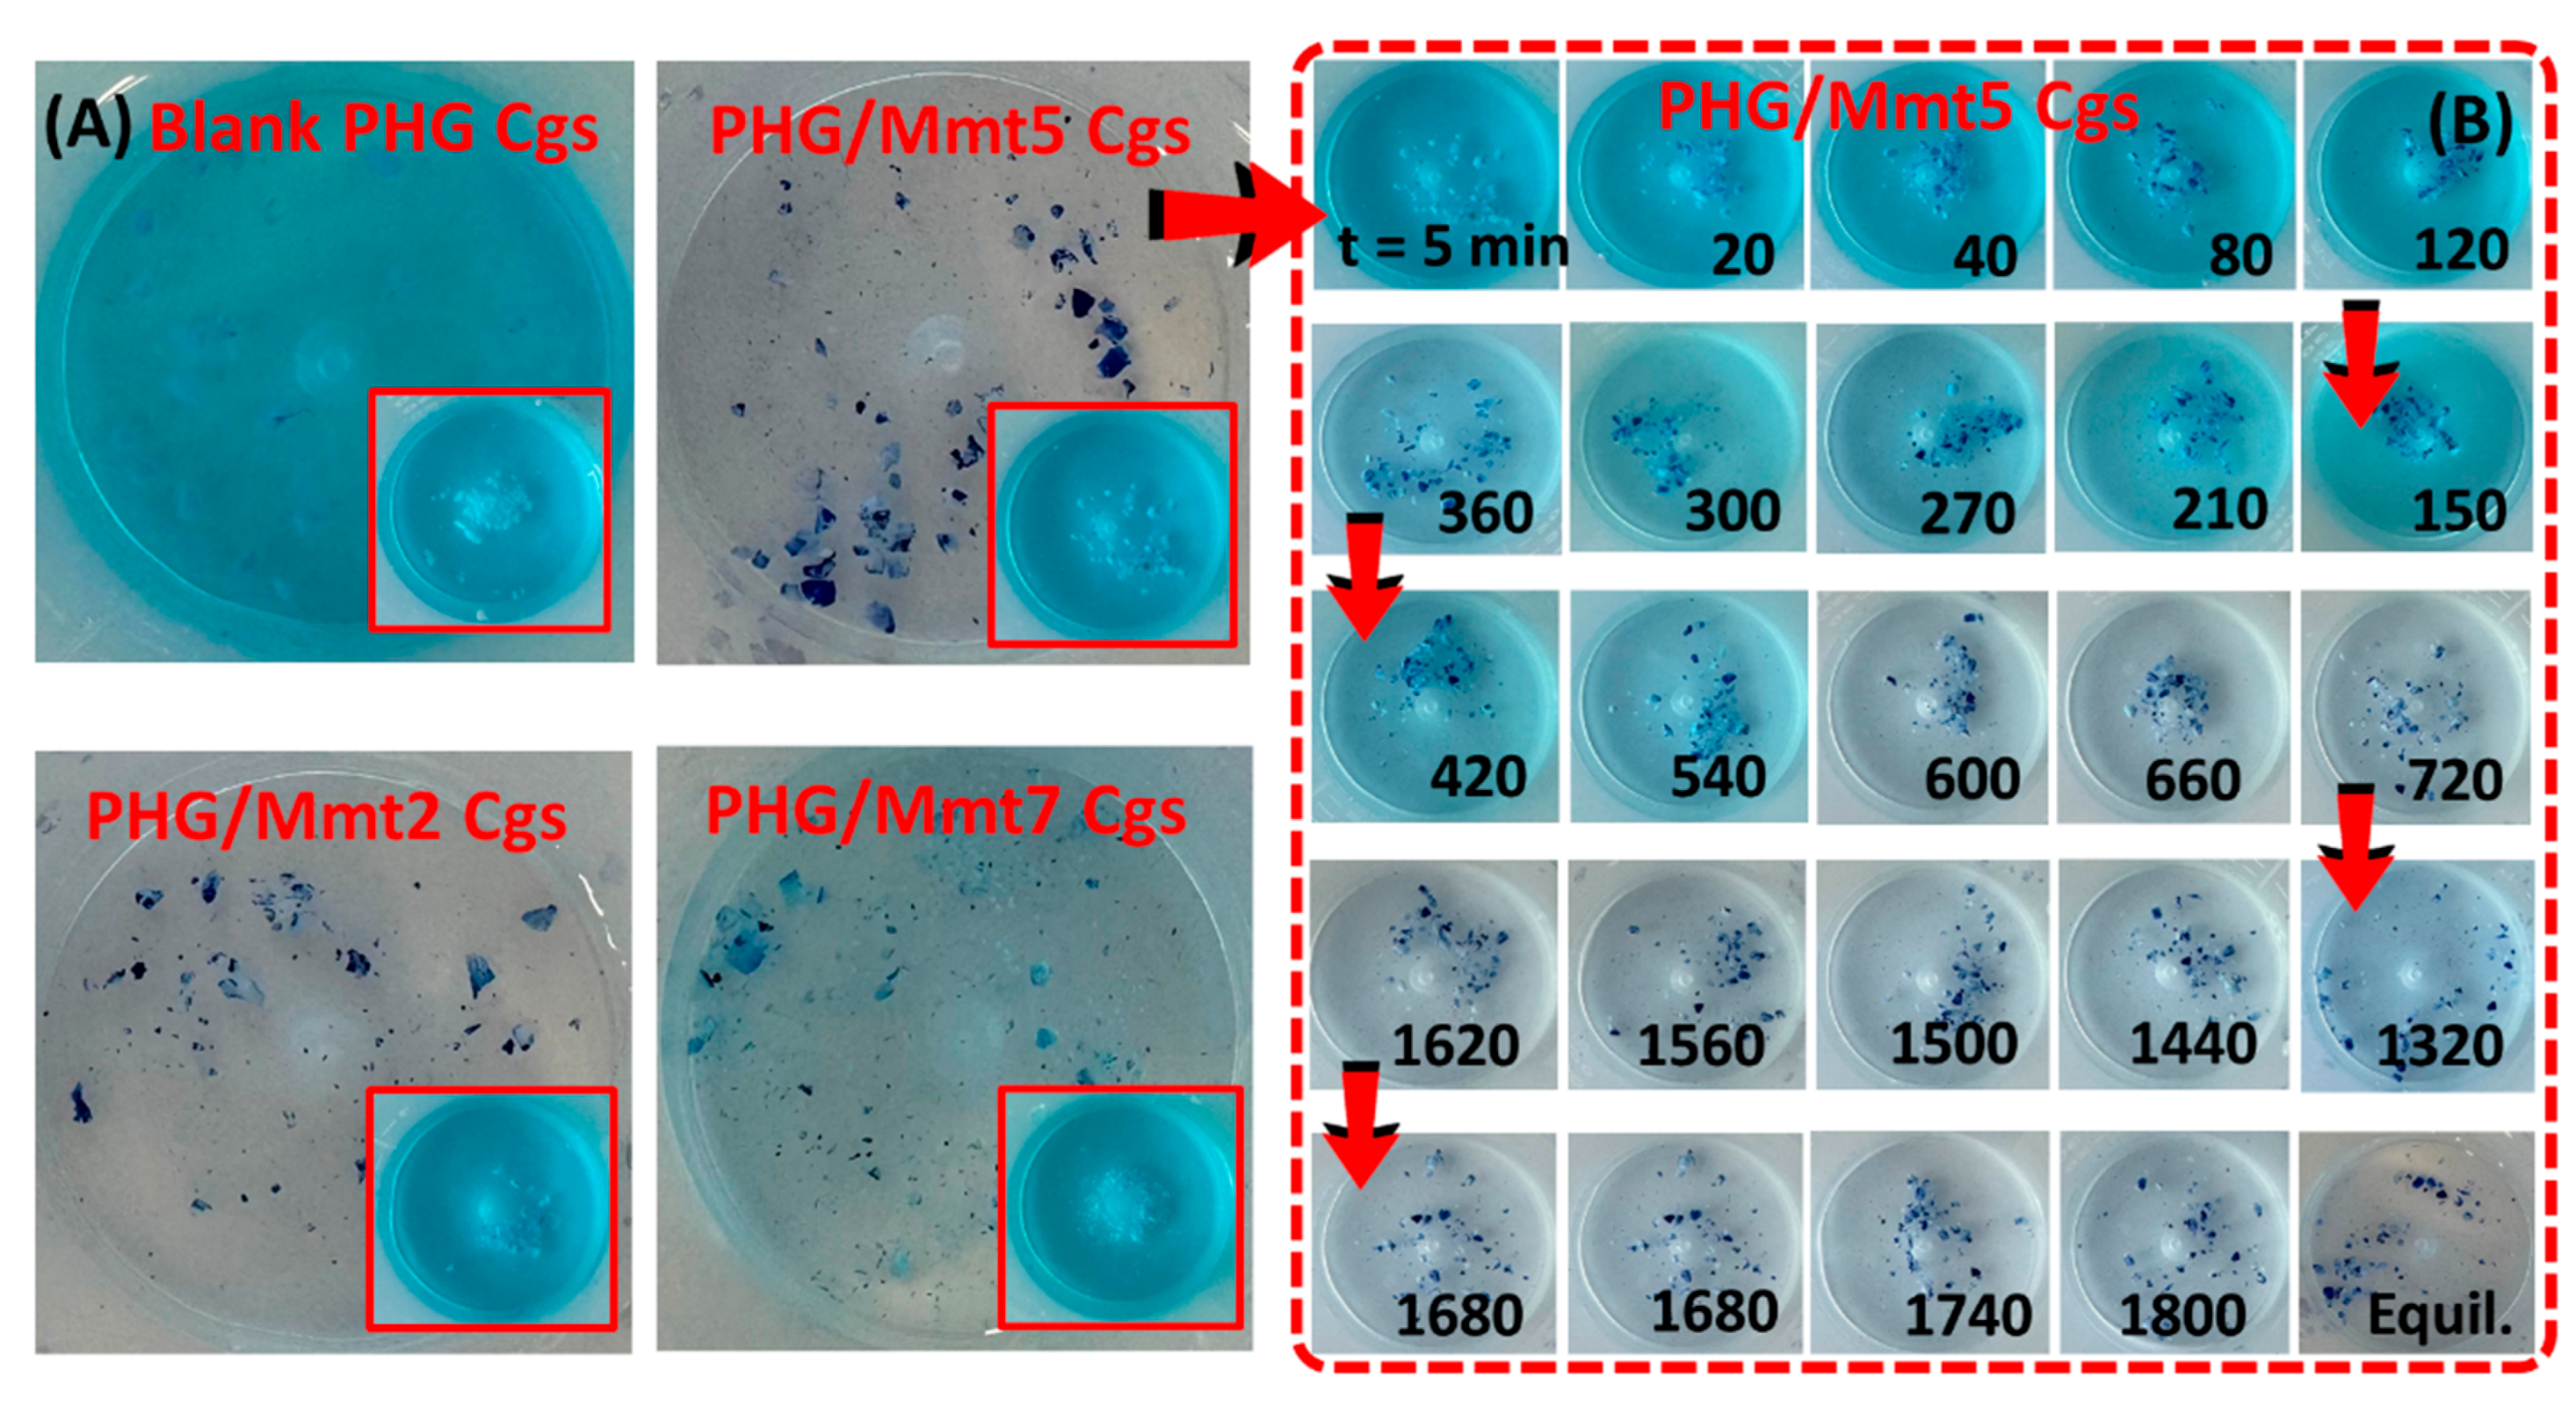
Gels 11 00803 g013

Innovative copolymeric poly(hydroxypropyl methacrylate-co-glycidyl methacrylate)/Montmorillonite (PHG/Mmt) hybrids containing functional epoxide and hydroxyl groups were synthesized by varying the aluminosilicate content in the hybrid structure. A perspective was established by examining the physicochemical properties of hybrids with nanoclay-integrated properties and their application as adsorbents in the treatment of dye wastewater.
2.1. Synthesis of Epoxy-Functional (Alkyl)methacrylate-Based Hybrid Gels
The formation of layered silicate-integrated epoxy-functional hybrid gels was achieved via the combination of in situ free-radicalic crosslinking copolymerization reaction with the blending method according to
Scheme 1. The concentration of nanoclay Mmt integrated into the copolymer poly(hydroxypropyl methacrylate-co-glycidyl methacrylate) network, in which the mol ratio of HPMA/GMA monomers was fixed as 80/20%, varied between 0 and 2.41% (
w/
v). The total monomer concentration in the feed for HPMA, GMA, and TEGDMA in the structure was set to 15.1% (
w/
v). In the synthetic protocol followed for the chemical crosslinking of the copolymer, the crosslinking ratio X, the mole ratio of TEGDMA to HPMA and GMA was fixed at 1/78 [
21].
Table S1 presents the composition of epoxy-functional hybrid gels prepared at various Mmt contents. Optical views of the clay solutions containing various Mmt just before the addition of monomer was also presented in
Scheme 1. For the clay-free blank copolymer synthesis, coded as PHG/Mmt0, the pre-gel solution was whitish opaque, and as Mmt content increased up to 2.41% (
w/
v), the yellowish opacity of the solutions also increased.
Table 1 shows the changes in the characteristic network parameters for hybrid hydrogels and cryogels depending on the amount of nanoclay Mmt in the hybrid composition. Upon completion of the crosslinking polymerization to remove the impurities by a water solvent exchange procedure, the cylindrical gel rods removed from the syringes were subjected to the swelling/drying stages to determine the structural parameters that characterize the network structure [
22]. Using the dry gel weights, the characteristic experimental values of
, defined as the volume fraction of the crosslinked polymer network after the preparation stage, and the change in gel fraction as a function of the Mmt content in the hybrid structure were calculated using Equation (1). The difference between the calculated theoretical values and the experimental values, depending on the synthesis conditions, was attributed to the presence of bound water remaining in the gel structure during the drying process. The high agreement between the theoretical and experimental values for hybrid hydrogels and cryogels, depending on the Mmt concentration, indicates the success of the synthesis. In
Figure 1, depending on the Mmt concentration, the gel fraction of hybrid PHG/Mmt hydrogels and cryogels varied between 89.96 (±0.61)–90.30 (±1.03) and 89.58 (±1.50)–91.77 (±1.75), respectively. Functional epoxy groups were introduced into the PHPMA structure by copolymerizing HPMA with GMA carrying an epoxy group.
Table 1 and the gel fraction values provide accurate data on free radical crosslinking copolymerization of PHG/Mmt gels over the entire range for Mmt concentrations. From
Figure 1, it is clear that free-radicalic polymerization produces high-yield hybrid networks, depending on the amount of clay used. This results in a simplification of the functionalization step, as the oxirane group in the GMA structure serves as an active site for effective covalent binding in the polymerization reaction.
In terms of polymerization kinetics, the studies have shown that GMA units in the structure have a faster polymerization rate than hydroxyethyl methacrylate (HEMA) [
23], as the HEMA units of hybrid structure provide the hydrophilicity of copolymer network while controlling the density of epoxy groups. The contribution of HPMA units to polymerization is due to the methacrylate groups in its structure, which lead to relatively easy radical reactions, while hydroxyl groups provide the hydrophilicity [
24]. In the hybrid structure, the carbonyl C=O group of HPMA monomer functions as a proton acceptor, while the hydroxyl –OH unit functions as both a proton donor and acceptor. Therefore, the hydrogen bond formation between the carbonyl oxygen atom and the hydroxyl group in the structure strengthens the partial charges on the carbonyl C atom, creating charge transfer. Both C=O···HO and OH···-type H-bonds can form between PHPMA units in the hybrid structure, with the possible contribution of the carbonyl units of GMA. For the H-bond formation in PHEMA, as a result of the analysis by temperature-dependent infrared spectroscopy, it was reported that 47.3% of the OH group in the terminal side chain of PHEMA participated in the OH···O=C hydrogen bond formation, while 53.7% contributed to the OH···OH hydrogen bond formation [
25]. The addition of Mmt platelets to the polymerization medium disrupts the HPMA-HPMA and HPMA-GMA interactions, creating more reactive molecules that increase the reaction rate during the polymerization. This results in higher kinetic rate constants and lower overall activation energies. Thus, preventing the formation of potential H-bonds between HPMA and GMA relatively increases the rate of monomer addition to the macroradicals. Because the preparation temperature of PHG/Mmt hydrogels synthesized at room temperature is higher, the formation of side H-bonds is not dominant, as monomer molecules and macroradicals have greater mobility. However, since the reactivity of radicals and monomer molecules decreases significantly at lower temperatures due to H-bond formation, the presence of Mmt platelets, which disrupt these bonds, will significantly contribute to the increased polymerization rate.
Ren and coworkers applied surface-initiated atom transfer radical polymerization to prepare poly(2-hydroxyethyl methacrylate)-block-poly(2-hydroxyethyl methacrylate-co-glycidyl methacrylate) brushes and followed the polymerization kinetics using quartz crystal microbalance [
23]. To control the density of epoxy groups, two GMA/HEMA ratios, 1:10 and 1:4, were examined in terms of the feed ratio between GMA and HEMA, and the results of bulk polymerization kinetics suggested the faster polymerization rate of GMA than HEMA. Zhao and coworkers reported the design of poly(hydroxyethyl methacrylate-co-glycidyl methacrylate)-grafted magnetic chitosan microspheres via reversed-phase suspension polymerization. The grafted GMA and HEMA were reported to reduce steric hindrance during binding by providing reactive epoxy groups, thus increasing enzyme immobilization capacity and preserving the activity by creating a hydrophilic microenvironment on the surface [
26]. The slight increase in the polymerization rate caused by Mmt integration into PHEMA was attributed to non-covalent interactions such as hydrogen bonding between the polymer and the nanoadditive in the medium. Achilias and Siafaka analyzed the formation of PHEMA-based nanocomposites via following in situ bulk radical polymerization kinetics in the presence of organomodified Mmt [
27]. The effect of nanofiller content on the double bond conversion and hence the polymerization rate over time at two different temperatures was investigated. The presence of nanoclay increased the polymerization kinetics, leading to higher conversion and the relative effective rate constant increased significantly with the amount of Mmt but showed a much lower increase at higher temperatures.
2.2. Structural Characterization of Epoxy-Functional Hybrid Gels
Figure 2 presents ATR-FTIR spectra of Mmt clay, blank PHG as a reference gel, and hybrid PHG/Mmt7 cryogel containing 2.41% (
w/
v) Mmt in the feed. For comparison, ATR-FTIR spectra of hybrid hydrogels are presented in
Figure S1 in Supplementary Materials. The broad bands observed at 3340 and 3386 cm
−1 in the spectra of blank PHG and hybrid PHG/Mmt7 cryogel were attributed to the stretching vibration of lateral hydroxyl groups, -OH-belonging HPMA units. The stretching vibration peaks detected at around 2979 and 2942 cm
−1 for blank PHG and at 2985 and 2933 cm
−1 for hybrid gels were attributed to -CH
2-, C-H, and -CH
3 bond stretching. For blank PHG gel, the absorption peak observed at approximately 1717 cm
−1 was due to the stretching vibration of the carbonyl groups, whereas after the addition of Mmt, the peak intensity at 1718 cm
−1 decreased due to the increased hydrogen bond interaction [
28]. For the blank PHG Cgs, the peak appearing at 1244 cm
−1 was detected as belonging to the C–O–C bond of the epoxy group, with decreasing intensity for the hybrid PHG/Mmt7 Cgs. The peaks at 1155–1156 cm
−1 attributed to -C-O- stretching vibration indicated the presence of -COO- ester groups in the prepared cryogels. The peak at 967 cm
−1 corresponding to the epoxy group of GMA for the blank PHG gel was detected as a shoulder around 964 cm
−1 in the hybrid PHG/Mmt7 Cgs spectrum.
In the spectrum of raw Mmt, the peak at 3632 cm
−1 was attributed to the presence of hydroxyl linkage, while the strong band at 3388 cm
−1 and the overlaid absorption peak at 1644 cm
−1 predicted the possibility of hydration of water or -OH bending mode of adsorbed water. The shoulder at 1207 cm
−1 was attributed to the bending mode of adsorbed water by Mmt, while the strong band at 1020 cm
−1 was observed due to Si–O–Si stretching (in plane) vibration for layered silicates. In the hybrid structure, the shoulder at 911 cm
−1 corresponded to the bending mode of -OH groups of Mmt via Mg-Al-OH linkage, and the shift in the peaks suggested that exchangeable Na
+ tends to settle preferentially into ditrigonal cavities over sites of ionic substitution through the octahedral sheet [
29]. The peaks in the range of about 760–790 cm
−1 in the hybrid spectrum are due to the stretching of the Mg-Fe-OH and Si-O-Si tetrahedral bridge bonds in SiO
2. Discrete differences observed in the shift and intensity of the absorption bands in the spectrum of hybrid compared with the clay-free copolymeric structure were a consequence of incorporating inorganic nanoclay Mmt as well as the crosslinking reactions. All these peaks confirmed that clay-free copolymeric as well as (alkyl)methacrylate-based hybrid gels have been prepared successfully.
2.3. Thermogravimetric Analysis of Epoxy-Functional Hybrid Gels
After the cylindrical gels were subjected to the solvent-exchange procedure in water to remove the impurities, they were dried and ground into powder to perform the thermogravimetric analysis for blank PHG and hybrid PHG/Mmt gels. The obtained thermograms were compared and discussed in terms of the changes observed in the co- and hybrid network structures resulting from the interactions between the functional groups and inorganic clay Mmt. In
Figure 3, the thermal curve for raw Mmt indicated the loss of interlayer water with 3.04% to about 112.4 °C, in which the mass loss reached its maximum at 51.5 °C [
30]. At 205 °C, the slope of curve started to decrease slightly through 600 °C, after which only 13.7% of water associated with the exchangeable cation was lost, and above 600 °C, a very small amount of water was evolved, namely 0.5%. The mass loss process in all samples takes place in two steps. For hydrogel samples of blank PHG and hybrid PHG/Mmt given in
Figure S2, the first step observed up to 202.8 and 208.2 °C with a mass loss of 9.6% and 7.4% due to the physical desorption of water from the surface, respectively. In the first region, the mass loss of cryogel samples of blank PHG and hybrid PHG/Mmt Cgs were 10.9% and 6.6% below 184.9 and 189.5 °C, respectively. For copolymeric PHG Hgs and Cgs, following the initial water loss, the second stage occurred in the range of 202.8–440.8 °C and 184.9–449.1 °C, respectively, with a mass loss of 95% and identical peak temperatures at 342 °C. The second decomposition region of hybrid PHG/Mmt Hgs was in the range of 208.2 and 450.5 °C with a corresponding peak temperature at 368.2 °C and mass loss of 94.9%. While for hybrid PHG/Mmt Cgs, the second decomposition region was observed between 189.5 and 453.1 °C with a mass loss of 96.2% and peak temperature at 325.6 °C, which was due to the thermal decomposition of side groups in polymer chains, the elimination of chain-end monomers, as well as the ester side-chain scissions. Moreover, a weak broad peak was observed for PHG Hgs and Cgs in the range of 210–270 °C as well as for hybrid PHG/Mmt Hgs and Cgs in the range of 180–260 °C due to the degradation of epoxy C–O–C groups in GMA units. Similar results were reported by Zhai and coworkers for P(HPMA-co-GMA) cryogels prepared in the presence of
N,N-methylenebisacrylamide as the crosslinker [
31]. All the hybrid gels synthesized in this study were thermally more stable than blank PHG gels according to the decomposition temperature as well as the residue at 800 °C.
Table 2 shows the thermogravimetric results collected and compared with blank PHG and hybrid PHG/Mmt Hgs and Cgs. The first derivative of the mass losses of all prepared Hgs and Cgs with respect to temperature showed the location of the maximum temperature Tmax, which increased with the addition of Mmt nanoclay. The hydroxyl group of PHPMA is able to interact with the GMA units, and the resulting interactions are responsible for the position of these maximum peaks. Depending on both the changing polymerization temperature and Mmt concentration, the residue of hydrogel samples at 800 °C was 1.4% and 3.6% for blank PHG and hybrid PHG/Mmt, respectively, while the residue of cryogel samples was 2.7% and 2.4%.
Tang and colleagues recently reported that Mmt nanoclay integrates into the network, acting as a barrier to hydrogel mobility and thus increasing the thermal stability. Therefore, poly(2-acrylamide-2-methylpropane sulfonic acid)/polyethylene glycol/montmorillonite (PAMPS/PEG/Mmt) hydrogels exhibited slower weight loss compared to the reference gel without clay. This suggests that the addition of Mmt increases the thermal stability of the hydrogels through the interactions between the ionic functional groups of Mmt and PAMPS [
32]. Jumpapaeng and coworkers prepared cassava starch-grafted polyacrylamide/natural rubber nanocomposites containing various Mmt contents (0–10 wt%) to investigate the effect of nanoclay addition on the thermal stability [
33]. The gradual increase in thermal stability with increasing amount of Mmt nanoclay was due to the formation of stronger physical crosslinks between the polymeric networks by acting as crosslinking agents of the -OH groups on Mmt.
XRD patterns of blank PHG as well as hybrid PHG/Mmt7 Hgs and Cgs are shown in
Figure 4. The interlayer spacing calculated from the reflection peaks according to Bragg’s equation; d = nλ/2sin θ, predicted that Mmt exhibits a characteristic reflection at 2θ 8.85°, which corresponds to a basal spacing (d
001) of about 9.9562 Å. The other peaks at 2θ 17.81° and 19.83° are impurities like quartz, which was further confirmed by the characteristic band at 792 cm
−1 in the ATR-FTIR spectrum of Mmt, and the presence of kaolinite was indicated by d-spacing peaks at 20.86° and 26.83° and the small broader shoulder around 34.93° [
34]. It is clear from the sharpness and intensity of the peaks in the spectrum that Mmt has a highly crystalline structure. However, the reflection of Mmt at 2θ 8.85° seemed to be diminished for hybrid PHG/Mmt7 Hgs and Cgs which exhibited an exfoliated structure. For copolymeric and hybrid hydrogel and cryogel samples, there was a marked similarity in the diffractograms in which the broad and low intensity bands indicated a low degree of crystallinity as well as a small crystallite size which is consistent with previously published data [
35,
36].
At 2θ degrees of around 17.85° and 18.31°, the broad and less intense bands were detected for the hybrid PHG/Mmt7 samples; however, similar bands with smaller intensity indicating the semi-crystalline regions were detected at 2θ = 7.75°, and 17.55° for the copolymer PHG Hgs and Cgs, respectively. A major X-ray diffraction peak at around 20.5° showing the crystalline region was recently reported by Yang and coworkers for HPMA grafted onto the surface of silk fabric to improve its crease resistance [
36]. Consequently, XRD results confirmed the formation of nanocomposites successfully by the exfoliation of Mmt where the layers were distributed unevenly between the network chains without interrupting the formation of crystalline regions. The polar groups in the blank and hybrid PHG/Mmt7 gels interact with the polar groups of Mmt clay, and the corresponding interaction results in the production of stronger and denser networks.
2.4. Elastic Properties of Epoxy-Functional Hybrid Gels
Figure 5 shows the equilibrium swelling ratio of Mmt-doped PHG/Mmt gels in water and the volume fraction of the crosslinked polymer network in the swollen hybrids as a function of Mmt concentration. Considering that HPMA is a more polar component than GMA units, the HPMA units in PHG structure help to maintain the network hydrophilicity.
Figure S3 shows the swollen-state images of hybrid PHG/Mmt hydrogels after their swelling in water. The swelling ratio of the hybrid gels prepared at −18 °C under low-temperature conditions was generally higher than that of hydrogels. The hybrid gels first tended to swell with increasing Mmt content up to 1.10% (
w/
v) and then decreased monotonically. The observed decrease is due to the nanoclay particles acting as physical crosslinking points within the PHG network, in addition to the chemical crosslinker TEGDMA.
The relatively increased crosslinking further reduces the free volume within the hybrid structure, making it more difficult for water molecules to enter, resulting in lower swelling rates. It is widely known that increasing the Mmt weight ratio up to 4% increases the water absorbency, while increasing it further decreases the absorbency. A similar decreasing trend was reported for PGMA/Na–montmorillonite nanocomposites prepared by changing the GMA content [
37]. The observed swelling reduction showed a monotonic change depending on the clay content added to the hybrid structure. As the polymer amount entering the layers reached a limit, the clay interlayers opened to their maximum, resulting in a crosslinked structure that prevents the water molecules from entering the structure.
To evaluate the effect of Mmt integration into the PHG matrix, the uniaxial compression testing was performed at 0.5 mm/min and room temperature after preparation stage and after their equilibrium swelling in water.
Figure 6 presents the isothermal compression curves of compressive stress as a function of the hybrid composition. Compared to the as-prepared state condition (
Figure 6A), the compressive stress required to compress the swollen PHG/Mmt hydrogels to 10% of their original size decreases (
Figure 6B) and also varies with the amount of inorganic nanolayers of Mmt added to the PHG structure. However, to compress the hybrid PHG/Mmt cryogels synthesized under cryoconditions to the same extent, greater compression force is required (
Figure 6C).
Figure S4 presents the optical images of blank PHG Hgs and Cgs during finger compression. The cryogels with sponge-like macroporous structure were typically synthesized by cooling the pre-gel solution at temperatures below the freezing point of the polymerization solvent. A significant portion of the pre-gel solution is concentrated, called cryoconcentration, in unfrozen liquid microphase, while a large amount of the solvent crystallizes and forms crystallized macro-phase. The cryoconcentration of pre-gel mixture makes cryogelling more efficient by reducing the critical concentration needed for cryogelation, and by this way, accelerating the gelation. The pre-gel mixture of higher polymer concentration increases the stiffness of cryogels and also results in the formation of a smaller average pore size. Upon crosslinking, the solvent crystals melt at room temperature, and this thawing process results in an interconnected macroporous structure formation. The pore size and interconnectivity mainly depend on the cryogelation conditions, the type and content of the monomers, the initial solvent crystallization temperature, the freezing point of polymerization solvent, the cryoconcentration of constituents in pre-gel, the extent and rate of crosslinking, and the temperature and duration of the cryogelation process [
38,
39,
40,
41]. The average gel strength was assessed by the compressive modulus after preparation
G0 and after the swelling-state obtained from Equation (3). The results, shown in
Figure 7, indicate that the
G values increase with the increase in Mmt concentration up to 2.20% (
w/
v). Then, at values above this content, the gel strength decreases, that is, the hybrids would become weaker when the Mmt content exceeds 2.20% (
w/
v). This is because excessive Mmt content due to agglomeration can cause the hybrid matrix to become discontinuous. The incorporation of 2.20% (
w/
v) Mmt resulted in a 10-fold increase in the elastic modulus of hybrid cryogels from 0.39 kPa to 40.1 kPa, while it resulted in a 4.3-fold increase in the modulus of hybrid hydrogels. The hybrid PHG/Mmt structure primarily consists of copolymeric PHG chains that interconnect adjacent Mmt layers, and the copolymeric chains are effectively crosslinked by the Mmt layers. In the blank PHG gel structure, the network chains are randomly crosslinked only by TEGDMA units, resulting in a wide distribution of length of the network chains between random crosslinking points. In contrast, the flexible polymer chains within the structure exhibit random conformations depending on the distance between the Mmt layers.
The chain lengths between the Mmt layers change proportionally to the distance between the clay particles, resulting in the unique polymer/clay network structure and exceptional mechanical properties. Similar results were reported in the study where the reinforcing properties of highly exfoliated Mmt/poly(glycidyl methacrylate) nanocomposites were determined, and dynamic mechanical measurements of reinforced epoxy matrix revealed that the addition of low amounts of nanofiller from 1% to 5% wt led to significant improvements in the mechanical properties and an increase in the storage modulus [
15]. In similar systems, the deterioration in the mechanical properties with increasing clay content was attributed to the formation of some particles formed as a result of the agglomeration of nanofillers. It was observed that the formation of larger particles was more pronounced in the composites containing 5% wt filler, weakening the mechanical properties. Nikolaidis and coworkers investigated the mechanical properties of organomodified montmorillonite (OMmt)/poly(methyl methacrylate) (PMMA) nanocomposites prepared by in situ bulk polymerization [
42]. Evaluation of the tensile measurements indicated an increase in the Young’s modulus and a decrease in the tensile strength and elongation at break, probably due to the formation of hydrogen bonds between the hydroxyl groups in clay and carbonyl groups in PMMA. Although the addition of clay increased the hardness of the hybrid system, the interface adhesion between PMMA and OMmt was not strong enough to withstand large deformations, leading to the premature failure of the nanocomposites and decreased the tensile strength.
2.5. Responsive Swelling Properties of Epoxy-Functional Hybrid Gels
Swelling properties of the prepared hybrids were examined in aqueous salt (NaCl) and surfactant (CTAC, SDS, and CTAB) solutions at different concentrations. While increasing salt concentration decreased the extent of swelling, increasing the Mmt content showed the same effect.
Figure 8 shows how the effect of salt concentration in the external solution on the swelling varies with the composition. The hybrid gels tended to reduce their volume by “salting-out” type swelling at all salt concentrations. For 2.41% (
w/
v) Mmt-doped PHG/Mmt7 hydrogel, the volumetric swelling decreased 2.1-fold from 13.780 ± 0.682 to 6.521 ± 0.585 by increasing the concentration of NaCl solution from 10
−5 M to 1.0 M. For the PHG/Mmt7 cryogel sample, the swelling was reduced by 1.5 times in the same range from 13.557 ± 0.747 to 8.593 ± 0.490. The comparison of shrinkage tendencies in 1.0 M salt solution showed that the hybrid cryogels have less tendency to collapse compared to the hybrid hydrogels due to their porous structure. In similar systems investigating the salt sensitivity of sulfonated polyacrylamide/sodium montmorillonite hydrogels containing different clay concentrations, it was reported that the nanocomposites showed lower salt sensitivity compared to unfilled gels [
43]. The reduction, which was more pronounced in the clay-free gels, was due to higher mobility of the network chains, thus exhibiting a higher deswelling behavior. Based on the swelling thermodynamics, different components of the free energy of hydrogels (mixing, elastic, ionic, and Coulomb free energies) vary with the salt concentration in the swelling medium. In the region of low salt concentrations, the elastic free energy of gels varies rapidly with the salt concentration, due to the strong coupling between the chemical and mechanical energy. However, in the region of high salt concentrations, it does not change significantly because of the weaker chemical–mechanical coupling as the network collapses. In their study, Zhang and colleagues experimentally investigated the potential of hydrogels to generate energy from salinity gradients, supported by a theoretical framework [
44]. By applying the mechanical pressure to delay the swelling or deswelling of hydrogels in saline solutions, a perspective on the conversion of free energy mixing into the mechanical work is presented. Under external pressure, the mechanical work per unit change in salt concentration is high for dilute solutions and decreases at high salt concentrations, where the effect of salt concentration on the hydrogel volume is minimal.
Surfactant-regulated swelling of hybrid PHG/Mmt gels was investigated in three different ionic surfactants: anionic SDS and cationic CTAC and CTAB with various concentrations.
Figure 9 compares the equilibrium swelling ratio of hybrid hydrogels depending on the type of surfactant, while the results of hybrid cryogels are presented in
Figure S5. The swelling pattern of the hybrids indicates that these gels exhibit good swelling performance with both anionic and cationic surfactants, with good stability. Considering the nature of the surfactants, the hybrid gels tend to swell more in cationic CTAB and CTAC solutions than in anionic SDS, with the highest swelling observed in CTAC solutions. Addition of inorganic Mmt to the PHG matrix reduced the swelling, regardless of the nature of the surfactants. In surfactant medium, the swelling capacity increased 1.2 times as a result of salting-in behavior in all surfactant solutions by changing the surfactant concentration between 5.625 mM and 37.125 mM. Nonionic gels exhibit properties similar to polyelectrolyte gels, as bound ionic surfactants at the gel interfaces create electrostatic interactions. The surfactants bound to the hydrophobic units of the network transform into hydrophilic units that interact specifically with adjacent water molecules, making the network more extensive. Lee and Bae proposed a thermodynamic framework for the swelling behavior of hydrogels in the ionic surfactants SDS and dodecyltrimethylammonium bromide, consisting of the specific interaction and interfacial contribution of the bound surfactant, which explains the effects of surfactant binding on the degree of swelling [
45]. The binding of hydrophobic tails from surfactants into the network structure results in the formation of aggregates that alter the interaction capabilities and interfacial properties. From the interface perspective, the monolayers formed by the ionic head groups of the bound surfactants contribute to the electrostatic and interfacial properties [
46]. From the polymer chain perspective, the substitution of hydrophilic units from surfactant aggregates significantly disrupts the interaction between the water and polymer gel. Due to the limited occupancy of binding sites by added surfactant molecules, the interaction ability depends on the proportion of occupied binding sites [
47].
2.6. Adsorption Properties of Epoxy-Functional Hybrid Gels
After the polymerization was completed, the small cylindrical samples were prepared from rod-shaped gels with a length of 60 mm and a width of 4.0–4.5 mm extracted from the polypropylene syringes and subjected to the swelling and elasticity tests; the samples were then dried, crushed, and turned into powder to be used in the adsorption experiments. The prepared hybrids were tested for their capacity to remove synthetic azo food dyes; tartrazine (E102), brilliant blue (E133), allura red (E129), carmoisine (E122), and sunset yellow (E110), which are popular as food colorants due to their low cost and stability, were compared with the cationic azo dye MB in
Figure 10. While the food dyes are important to the food industry primarily due to their coloring properties related to their chemical structure, azo dyes play a key role. From an environmental perspective, the dye waste degrades the water quality, causing serious health problems, particularly for humans, plants, animals, and aquatic life. The environmental importance of using food dyes is that their waste affects the aquatic ecosystems and contaminates drinking freshwater. Various in vivo and in vitro studies, based on acceptable daily intake data and food dye toxicology research, have also demonstrated dye toxicity [
48]. Carcinogenic substances in some food dyes damage cells, leading to a higher risk of health problems such as cancer, and can increase hyperactivity in children and cause allergic reactions. While it is possible to replace synthetic dyes with natural colorants, the technological and economic advantages of azo dyes may outweigh the advantages of natural dyes when commercialized as colorants for the food industry [
49]. Therefore, the effectiveness of the prepared (alkylmethacrylate)-based hybrids as alternative adsorbents in removing cationic and anionic dyes was evaluated and the adsorption of these dyes by the same adsorbent was compared. It is believed that this will enable the understanding and comparison of the dye-classified adsorption process for a fixed system. In comparison to anionic dye removal of different food dyes in water at 20 mg/L concentration, the highest adsorption was observed in brilliant blue (80.4%) and the lowest adsorption was observed in carmoisine (35.8%). Although the efficiency for other food dyes was sunset yellow (65.4%), allura red (56.2%), and tartrazine (51.2%), the adsorption kinetic studies were continued with MB dye based on the effectiveness of cationic MB dye being 92.3%. The permanent negative charges on the surface of Mmt platelets and the pH-induced charges on OH sites at the fracture edges cause charge heterogeneity, leading to different activities towards dyes. In their study comparing the adsorption of sulforhodamine G, rhodamine B, orange II, and MB onto Mmt, Fang and coworkers reported that the Al
3+ polarization of the edge hydroxyls caused a water molecule to bridge a tertiary amine group on RhB to a hydroxyl group on the edge surfaces of Mmt. The importance of high polarity edge hydroxyl in the complex formation, hydrogen bond formation and its effects on the adsorption of nitrogenous dyes, and the role of edge surfaces in the adsorption process are stated in [
50].
For the evaluation of the point of zero charge (PZC) of the prepared hybrid structures by characterizing pH-dependent charge change in edge regions in the present Mmt-doped hybrid system, the variation in ∆pH with respect to the initial pH is given in
Figure 11A. The Mmt layers have permanent negative charges in the basal planes due to the isomorphic substitutions, which cause the development of charges in the octahedral Al–OH and tetrahedral Si–OH groups at the edges depending on pH variation. These amphoteric sites are conditionally charged, supporting adsorption by developing variable positive or negative charges at the edges through direct H
+ or OH transfer from the aqueous phase, depending on pH. As seen in
Figure 11A, the edge OH groups have a PZC of 7.22 for PHG/Mmt7 Cgs less acidic than the Si–OH groups and less basic than the Al–OH. At pH < 7.22, the surface of the PHG/Mmt matrix becomes positively charged in a protonation reaction of Al–OH sites at edges through the reaction Si-OH + OH- → SiOH
2+ and Al-OH + H
+ ⇔ Al-OH
2+ and suitable for the adsorption of anionic dyes such as sunset yellow, allura red, brilliant blue, carmoisine, and tartrazine. At higher pH values by deprotonation of Si–OH than that of the Al–OH sites, the negative charging at edges through the reactions Si-OH + OH
− ⇔ Si-O
− and Al-OH + OH
− ⇔ Al-O
− increases the activity towards cationic dyes such as MB. Tombacz and Szekeres modeled the charge evolution at the edges and interpreted the pH-dependent surface charge heterogeneity. By analyzing the specific effect of pH on the surface charge of Mmt dispersed in different electrolyte solutions, the zero charge point of edge regions (pH
PZC, edge) was determined as pH 6.5 [
51].
Figure 11 illustrates the way solution pH affects the cationic MB dye adsorption of Mmt-doped hybrid gels. pH has a significant impact on the adsorption process, with the dye removal efficiency of hybrid gels increasing from 59.7% to 87.9% as pH increases. The increase in the number of negatively charged adsorbent sites is due to the increasing deprotonation of the silanol groups on the surface as the pH of the adsorption system increases. The presence of excess H
+ ions competing with dye cations for the adsorption sites is reflected in the decrease in MB adsorption at acidic pH. The interaction with the cationic dye decreases due to the higher amount of positive charge at the edges of the Mmt lamellae as the pH decreases.
Figure 11C presents the color change in the MB solutions in different pHs. As the pH decreases, adsorption efficiency weakens due to the attraction between the positively charged edges and the negatively charged basal plates, which becomes stronger. The relatively high removal rate observed in pH 2 medium (below 60%) is due to the surface hydrogen bond formation between the nitrogen atoms on methylene blue and hydroxyl group on the clay surface. For the present hybrid PHG/Mmt gels, the maximum uptake of MB occurs around pH 10; therefore, the subsequent adsorption kinetics and isotherm tests were carried out at this pH condition. Almedia and coworkers also obtained similar results for the removal of MB from colored wastewater by adsorption onto the Mmt clay; the adsorbed percentage of MB increased with pH and was maximum at pH 11 [
52].
2.7. Adsorption Kinetics of Epoxy-Functional Hybrid Gels
Adsorption kinetics was studied using experimental models to determine the reactions and extent of interactions occurring between the adsorbate and adsorbent. Adsorption kinetics were performed using 10.00 mg (±0.06) of blank PHG gels and hybrid PHG/Mmt Cgs with Mmt doping at 1.11%, 2.01%, and 2.41% (
w/
v) Mmt concentrations. The mass optimization was performed by ensuring that these gels were added to an initial concentration of 10 mg/L for cationic MB solutions with a solution volume of 10 mL at pH 10 and 22.5 °C. The experimental data for MB removal by blank PHG (
Figure 12A), PHG/Mmt2 (
Figure 12B), PHG/mmt5 (
Figure 12C), and PHG/Mmt7 (
Figure 12D) were fitted to the nonlinear kinetic models of Pseudo-first order (PFO), Pseudo-second order (PSO), and the Avrami and Elovich kinetic models (
Table 3). To determine the mechanistic behavior of the process, the experimental data were examined by a regression of intraparticle diffusion onto a multiple linear model, as shown in
Figure S8. These kinetic models are mathematically represented as Equations (S1)–(S5) in
Table S2. Adding hybrid gel to the MB solution gradually increased the adsorption efficiency as the exposure time increased. The equilibrium was reached after 24 h, and the results revealed that the integration of Mmt enhanced the dye removal efficiency of the PHG structure.
Figure 13 presents the color change in the solutions in time.
Figure S7 also presents the optical views of time-dependent adsorption of blank and hybrid PHG/Mmt cryogels containing various amounts of Mmt in the feed. The most effective removal was observed in the PHG/Mmt5 hybrid cryogels containing 2.01% (
w/
v) Mmt, while the decrease in the adsorption observed with increasing Mmt can be attributed to the saturation effect. The addition of more Mmt to the PHG structure reduces its ability to adsorb additional dye molecules, resulting in a slower adsorption process.
Based on the nonlinear fittings presented in
Figure 12, the kinetic parameters for the adsorption of MB onto Mmt-doped hybrid cryogels were collected in
Table 3 for the PFO, PSO, Elovich, and Avrami models. The nonlinear regression data, evaluated using the adjusted coefficient of determination (R
2), showed good fit for all models examined except PFO. In this model implemented using Equation (S1), the PFO constant
k1 (min
−1) is related to the adsorption rate and 1/
k1 shows the required time for the process to reach the equilibrium. In the hybrid structure,
k1 increased as the Mmt concentration increased, but the decrease observed in PHG/Mmt7 gel at the highest Mmt content resulted in an increase in the time required to reach the equilibrium, as clearly seen in
Figure 12D. However, the best fit was obtained with the Avrami model, which showed the highest
R2 values among the four systems evaluated. Comparing the
R2 values of PFO and PSO models with increasing Mmt, the PSO model gives higher values in all gel systems and the adsorbed amount at equilibrium
qe values match better with the experimental values. The adsorption data of MB removal were well fitted by PSO kinetic given by Equation (S2) in
Table S3. The equilibrium rate constant values of pseudo-second adsorption,
k2 (g/mg min
−1), calculated by this model for PHG/Mmt5 cryogel, showed that the initial rate was 2.18 × 10
−3 (g/mg min
−1) and the amount of MB adsorbed at equilibrium was 2.6247 mg/g, which agreed well with the experimental data (2.6036 mg/g) as presented in
Table S2. Based on the Avrami kinetic model, Equation (S3) was applied to the experimental data to calculate the Avrami kinetic constant
kAv and compare with the
k2 values calculated from the PSO model. Although both models describe the kinetic mechanisms, the constant
kAv provides a more accurate assessment of mechanism compared to the constant
k2, based on the independence of the Avrami constant from the initial adsorbate concentration (min
−1). The PSO constant is highly dependent on the initial adsorbate concentration in the solution (g mg
−1 min
−1). In addition, the Avrami kinetic model is fractal in type, describing a kinetic system with a time-dependent rate coefficient. Therefore, while the value of
nAv can be integer or fractional, when
n = 1 the model corresponds to the PFO model. While this value was 0.8350 for the blank gel, the values ranging from 0.5629 to 0.6569 were obtained for the Mmt-doped gels. The adsorption process changes with time depending on the effect of the contribution from multiple stages in the dominant mechanism on the total adsorption rate. Based on the Elovich model, using Equation (S4), the parameters
α and
β which are the initial adsorption rate and the desorption constant, respectively, were determined. While the initial adsorption rate increased with the addition of Mmt, a decrease was observed at the highest Mmt addition.
The intraparticle diffusion model was applied using Equation (S5) in
Table S2 to explain the adsorption mechanism of MB dye onto Mmt-doped PHG/Mmt cryogels, and the fit results of the experimental data are presented in
Figure S8 for comparison. The model indicates a linear adsorption profile encompassing two distinct stages, each represented by a linear equation in
Figure S8 for each system. The two stages seen in the plots are attributed to the mass transfer phenomenon underlying MB adsorption: the first stage, with a sharp slope, corresponds to the diffusion of MB molecules into the hybrid PHG/Mmt, while the second stage, with a lower slope, corresponds to the intraparticle diffusion of the dye. In
Figure S8, values of
C ≠ 0 indicate that the diffusion resistance dominates the adsorption process, while higher
C values indicate a greater influence of the boundary layer on the overall adsorption rate, as in the case of PHG/Mmt5 cryogel. Therefore, the external diffusion appears to be the limiting step in adsorption. The decrease in
C values with increasing Mmt content, as observed for PHG/Mmt7 Cgs, indicates that the mass transfer process is governed by the intraparticle diffusion and that the adsorption capacity varies proportionally to the square root of time. Application of the experimental data to the intraparticle diffusion model indicated that the adsorption process occurs in two stages, with an increase in the transition time between stages I and II observed with increasing Mmt content. Therefore, while the MB adsorption rate varies between stages, it also suggests that the mechanism controlling the dye diffusion rate dominates each stage. A similar observation was reported recently by Santos and coworkers for MB adsorption onto sodium zeolites. The intraparticle diffusion model significantly influenced the intraparticle diffusion of the boundary layer, highlighting the short transition time between the stages [
53].
The adsorption equilibrium was analyzed by changing the initial concentration of MB solutions at pH 10 in the range of 5 to 25 mg L
−1. The equilibrium adsorption capacity of Mmt-doped hybrid PHG/Mmt5 Cgs was calculated using Equation (4). Considering the calculated adsorption capacity and the equilibrium concentration values, the isotherm curves were plotted as
qe versus
Ce in
Figure 14A and applied to the nonlinear models of Langmuir and Freundlich as two-parameter isotherms, as well as to the Redlich–Peterson, Sips, and Toth model as three-parameter isotherms, using the model equations presented in
Table S4. The change in dye adsorption capacity of the hybrid PHG/Mmt5 Cgs sample at initial MB dye concentrations ranging from 5 mg L
−1 to 25 mg L
−1 is shown in
Figure 14A. The maximum dye adsorption capacity for the hybrid network increased from 5.01 to 16.42 mg g
−1, while the higher dye removal capacity ranged from 65.7% to 98.9%. The intermolecular forces that developed between the adsorbent and the dye, which facilitated the movement of the dye molecule to the adsorbent surface, increased the removal capacity. This behavior is in agreement with previous results obtained for MB-immobilized poly(glycidyl methacrylate-co-methyl methacrylate) polymer composites. As the MB content increases linearly between 8 and 40 ppm, the polymer composites reach the highest value, i.e., 3.94 mg/g [
54]. In addition, considering the negative effect of the increase in the amount of polymer on the amount of immobilized MB, changing the time from 5 min to 30 min had a slight effect by decreasing the amount of MB from 3.65 mg/g to 3.94 mg/g.
Fitting Langmuir model using Equation (S6) in
Table S3, the parameters
KL (L/mg) and
RL defined as the Langmuir adsorption constant and Langmuir separation factor, respectively, were determined (
Table 4). This model describes the adsorption process as monolayer adsorption on a homogeneous material surface with the same affinity of binding sites. The
KL value was 0.7985, and the calculated
RL value for MB dye adsorbed by hybrid gels was within the range of 0.0437–0.1860, indicating that the adsorption process was easily achieved, as these values were between 0 and 1. However, in the Freundlich model described by Equation (S7), the adsorbent is assumed to have a heterogeneous surface and the adsorption process is considered interactive. Comparing the results obtained for these two models shows that the higher value for the correlation coefficient for hybrid cryogels,
R2 = 0.9734, is obtained in the case of the Freundlich model. This result indicates that the Mmt-doped hybrid cryogel has a heterogeneous surface that allows the interactive adsorption of MB molecules, and it can be concluded that its chemical versatility based on 2.01% (
w/
v) Mmt doping leads to adsorbent–adsorbate interactions. In
Table 4, the parameter
nF (5.0687) being between 1 and 10 indicates the suitability of the physical adsorption process, while the value of
KF (10.230) indicates the high adsorption capacity of MB by the hybrid cryogel.
The three-parameter models, Redlich–Peterson, Sips, and Toth isotherms, also showed good fit to the experimental data, with
R2 values compared to those given in
Table 4. The highest correlation was achieved with the Redlich–Peterson model, while the correlation was lower in the Toth model. Directly comparing two- and three-parameter adsorption isotherms is difficult because each model has different complexity and is formulated based on different hypotheses regarding the adsorption mechanism. Comparisons between the isotherm models with different parameters must be supported by physicochemical interpretation. The Redlich–Peterson isotherm, derived from the Langmuir and Freundlich isotherms, is a versatile model for both homogeneous and heterogeneous systems because it predicts dynamic equilibrium over a wide concentration range. The Redlich–Peterson isotherm approaches ideal conditions of Langmuir isotherm at low concentrations, while it approaches Freundlich isotherm at higher concentrations. Similarly, the Sips isotherm model, a combination of the Langmuir and Freundlich models, addresses the limitations associated with the Freundlich isotherm resulting from increasing adsorbate concentration and is based on describing heterogeneous systems with the heterogeneity factor. Setting the
ns value of 5.0699 in the Sips results implies the multiple adsorption sites/heterogeneous adsorption sites, converging the results to the Freundlich model. In
Table 4, the parameters β
RP = 0.1135 and
nS = 5.0699 obtained from Redlich–Peterson and Sips models show that the isotherms did not converge to Langmuir because they differed from 1. Therefore, the interactions between cationic MB dye and Mmt-loaded hybrid matrix are best represented by Freundlich isotherm. A similar observation was reported by Tong and coworkers for the adsorption of MB from aqueous solution onto porous cellulose-derived carbon/montmorillonite nanocomposites. Their findings are in better agreement with the Redlich–Peterson model of equilibrium adsorption [
55].
2.8. Adsorption Mechanism Analysis of Epoxy-Functional Hybrid Gels
FTIR was used to analyze the molecular structure of MB dye and Mmt-integrated hybrid gel before and after MB adsorption (
Figure 15). The absorption peak with a maximum at 3218 cm
−1 was due to the O–H stretching vibration, while the stretching vibration of C–H in methylene was observed at 3028 cm
−1. The skeletal stretching vibration of benzene ring was observed with a strong absorption peak at 1567 cm
−1. The characteristic stretching vibration of C–N in aromatic amines was observed at 1487 cm
−1 and 1393 cm
−1, while the stretching vibration of C–N in aliphatic chain was detected at 1149 cm
−1. The split peak with a maximum at 1327 cm
−1 is attributed to the asymmetric and symmetric stretching vibration of –CH
3, while the peak at 867 cm
−1 belongs to the absorption of in-plane bending vibration of C–H [
56]. After sorption of the MB dye, the intensity and displacement in the hybrid gel spectra changed slightly, but no new peaks formed, indicating that the adsorbent functional groups remained unchanged. After adsorption, the tensile vibration of C–N in the aliphatic unit near 1149 cm
−1 both increased and shifted to 1144 cm
−1. The displacement of the adsorption peaks is observed due to the weakening of stretching and torsional vibrations by the functional groups with increasing volume. The peak intensity at 1389 cm
−1 belonging to the symmetric bending vibration of CH
3 groups in the dimethylamine groups increased, while that at 1391 cm
−1 decreased [
57]. Similarly, after adsorption, the intensity of the peak at 1049 cm
−1 decreased, while the intensity of the peak at 991 cm
−1 increased significantly, indicating that the absorbance bands of Mmt integrated into the structure around 1049 cm
−1 and 1006 cm
−1 are due to vibrations caused by out-of-plane stretching and in-plane stretching of Si-O bonds, respectively. These results suggest that the possible mechanisms for MB adsorption by the Mmt-doped PHG/Mmt gel include the dipole–dipole hydrogen bonding, n-π interaction, and Yoshida hydrogen bonding. In their work, Li and coworkers suggested that hydrogen bonding may not be an important process for MB adsorption in the low-charge Mmt [
58]. It has been reported that the parallel orientation of the OH groups may prevent the formation of extensive hydrogen bonds between OH and N when the MB molecules are in a horizontal orientation. Another potential mechanism is the electrostatic interactions between charged groups in Mmt units in hybrid structure and charged groups in MB dye.